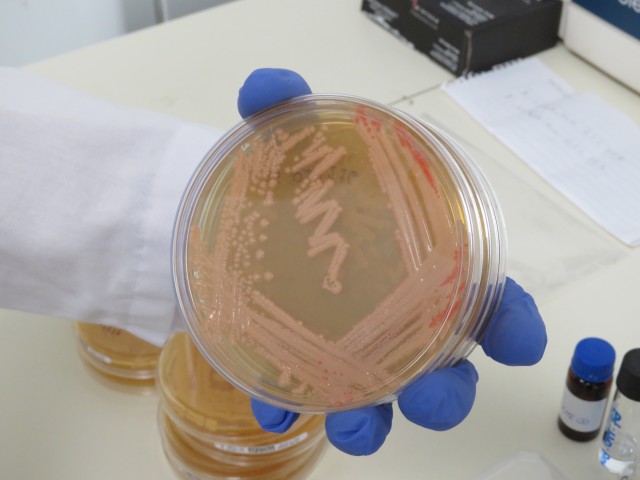
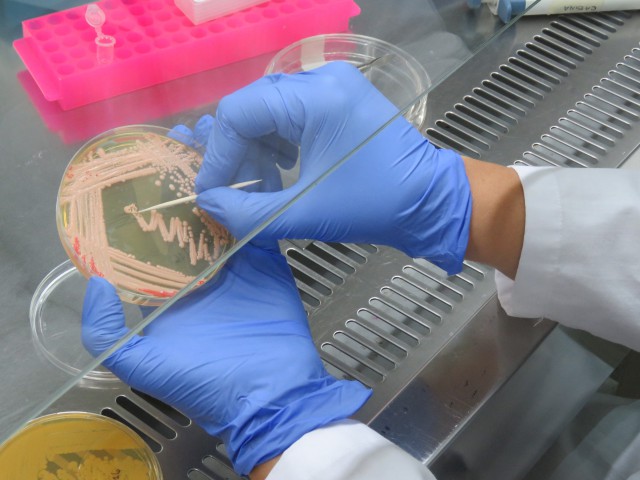

Luego de superada la etapa de Puesta a Punto, en la que intervinieron especialistas nacionales e internacionales, el nuevo equipamiento ubicado en la planta baja de la Facultad de Bioquímica y Ciencias Biológicas (FBCB) ya brinda servicios específicos a diferentes usuarios.
Durante el 2016 las actividades estuvieron enfocadas en la calibración del equipamiento, la preparación de los protocolos y los procedimientos de gestión para la solicitud de servicios. Hoy las determinaciones que se ofrecen corresponden a identificación de microorganismos y análisis proteómico, es decir, el estudio de proteínas, en particular de su estructura.
“Ya se han procesado aislados de microorganismos de muestras ambientales, de utilidad en industria láctea, por ejemplo” explica Adriana Ortolani, secretaria de Ciencia y Técnica de la FBCB.
Por su parte Javier Lottersberger, decano de la Facultad, expresó: "contar con un laboratorio que contiene tecnología de avanzada representa una gran responsabilidad porque se deben articular las actividades científicas con las necesidades de la región. La meta que nos ocupa no sólo es la formación de académicos, científicos y profesionales sino también convertirnos en partícipes del desarrollo orientado hacia el bien de nuestra sociedad”, y agregó “hoy tenemos un equipo de gente que trabaja y se esfuerza para lograr resultados de calidad en nuestros servicios".
Avance tecnológico para la comunidad
El MALDI-TOF es un equipamiento de alta complejidad, segundo en el país, de origen japonés que fue adquirido con fondos provinciales, a través del Ministerio de Ciencia, Tecnología e Innovación Productiva. Estos fondos formaron parte del programa provincial de apoyo a la investigación científica y transferencia de tecnología al sistema socio-productivo.
El objetivo primordial de este Programa es la posibilidad de ofrecer el servicio a instituciones públicas y privadas. De acuerdo a lo establecido en el plan de Gestión que fuera aprobado por la Agencia Santafesina de Ciencia, Tecnología e Innovación en 2014, se constituyó un Comité Ejecutivo que está integrado por el director del proyecto, Javier Lottersberger y los coordinadores de Investigación, Alberto Iglesias; de Gestión, Jorge Guillermo Ramos, y de Vinculación, Andrea Quiberoni. También intervienen representantes de las Facultades e Institutos de doble dependencia (UNL-CONICET) que participaron en la formulación de la propuesta. En este marco se busca establecer un mecanismo de trabajo conjunto para realizar determinaciones de referencia para todos los grupos que hagan investigación y desarrollo de instituciones públicas y privadas de la región.
Al respecto Ortolani dijo “mantuvimos reuniones con equipos de la Red de Laboratorios de la Provincia a los efectos de comenzar a trabajar en la coordinación de acciones para la prestación de servicios de identificación de microorganismos para el sistema de salud”.
El laboratorio próximamente contará además, con el servicio en el área de la Proteómica, Lipidómica y de perfiles de hidratos de carbono.
Quiénes pueden acceder al servicio
Los potenciales usuarios del equipamiento se agrupan en 3 categorías
Usuario A: Docentes, investigadores UNL, investigadores doble dependencia UNL-CONICET
Usuario B: Organismos Provinciales, Hospitales públicos, otras Universidades, CONICET de otras dependencias.
Usuario C: Empresas, Clínicas, Sanatorios Privados, Profesionales, Etc.
El servicio se brinda a todo el país, bajo un procedimiento de envío de muestras que preserve la bioseguridad de las mismas en el transporte y la correcta recepción de las mismas.
Datos de contacto
Para acceder a los servicios ofrecidos por el Laboratorio de Espectrometría de Masas dirigirse al 0342-4575206 interno 130, de lunes a viernes de 10 a 18 hs., o al correo electrónico maldi-unl@fbcb.unl.edu.ar.
La operadora del Laboratorio acordará con el potencial usuario una entrevista donde se le explicarán los aspectos básicos del análisis y las precauciones a tener en la toma de muestra y condiciones para el envío.